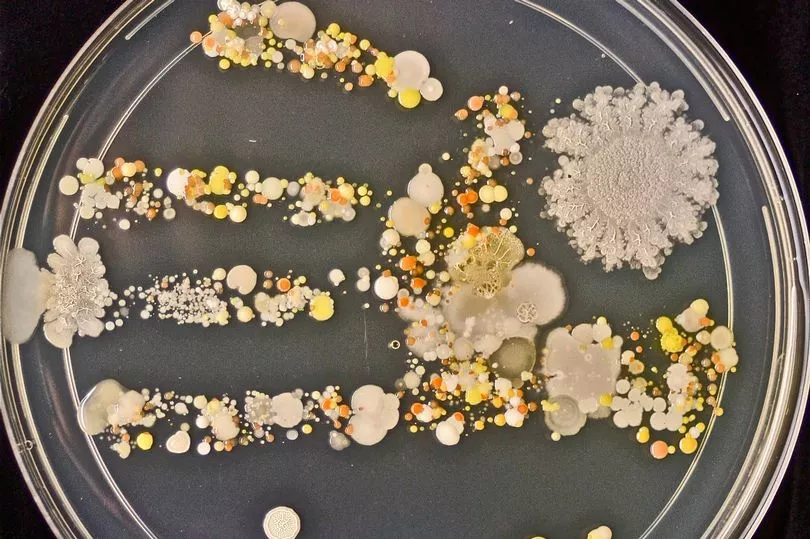

It's not that. These clowns are fucking broke man and under pressure. Remember, states ain't the federal government. States can't just print money. What we are seeing is states opening up to stop from going deeper in debt. You also have business owners who need to be open to get that PPP money forgiven. Business owners and politicians >>>>>> joe sixpack.
Now more than ever people have to be more involved locally and stop worrying about the White House. Write representatives. Stay on their asses. States are fucking this up big time and are getting away with it because too many who want to be cautious are focused on the orange bitch.
 Ohio went from being the first to treat this seriously to opening bars next week with this thing still raging. Why? State is broke and the loudest voices getting at state officials been the ones financially impacted. That's all local officials are hearing from. That's the pressure. Same in other states. Two types of pressure. People who are fed and have money focusing on the federal government. Folks who are broke and starving going at local politicians.
Ohio went from being the first to treat this seriously to opening bars next week with this thing still raging. Why? State is broke and the loudest voices getting at state officials been the ones financially impacted. That's all local officials are hearing from. That's the pressure. Same in other states. Two types of pressure. People who are fed and have money focusing on the federal government. Folks who are broke and starving going at local politicians.
This entire situation is a mess. Protect yourselves and families out here. Let these fools have their restaurants, bars, gyms, etc.


 www.cbsnews.com
www.cbsnews.com







 @ social distancing. I think we already know there are more than enough people who give a fuck about social distancing. They having house parties out the ass up here in Cleveland and the surrounding suburbs. Underground spots in the hood popping like crazy. Police don't give a fuck.
@ social distancing. I think we already know there are more than enough people who give a fuck about social distancing. They having house parties out the ass up here in Cleveland and the surrounding suburbs. Underground spots in the hood popping like crazy. Police don't give a fuck.